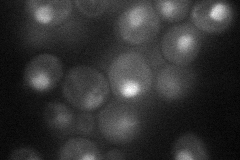
YBL008W
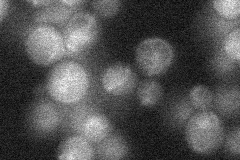
YBL008W
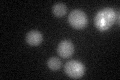
YBL008W
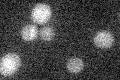
YBL008W

View description
Subunit of the HIR complex, a nucleosome assembly complex involved in regulation of histone gene transcription; contributes to nucleosome formation, heterochromatic gene silencing, and formation of functional kinetochores
Localization:
Intensity:
Fold change:
Significance:
-
C’ GFP library in SD

below threshold17.2 -
N' NOP1pr-GFP in SD
punctate,nucleus33.0121 -
N' TEF2pr-mCherry in SD

punctate,nucleus6.9719 -
N' NATIVEpr-GFP in SD
below threshold21.0073 -
N' TEF2pr-VC and Cyto-VN in SD

#N/A0 -
C’ GFP library in SD+DTT
cytosol17.050.99No -
C’ GFP library in SD+H2O2

cytosol14.980.87No -
C’ GFP library in Starvation Media
cytosol14.510.84No -
C’ GFP library on the background of Pup2-DaMP

below threshold -
C’ GFP library on the background of CCT mutant

below threshold17.51011.01767No
